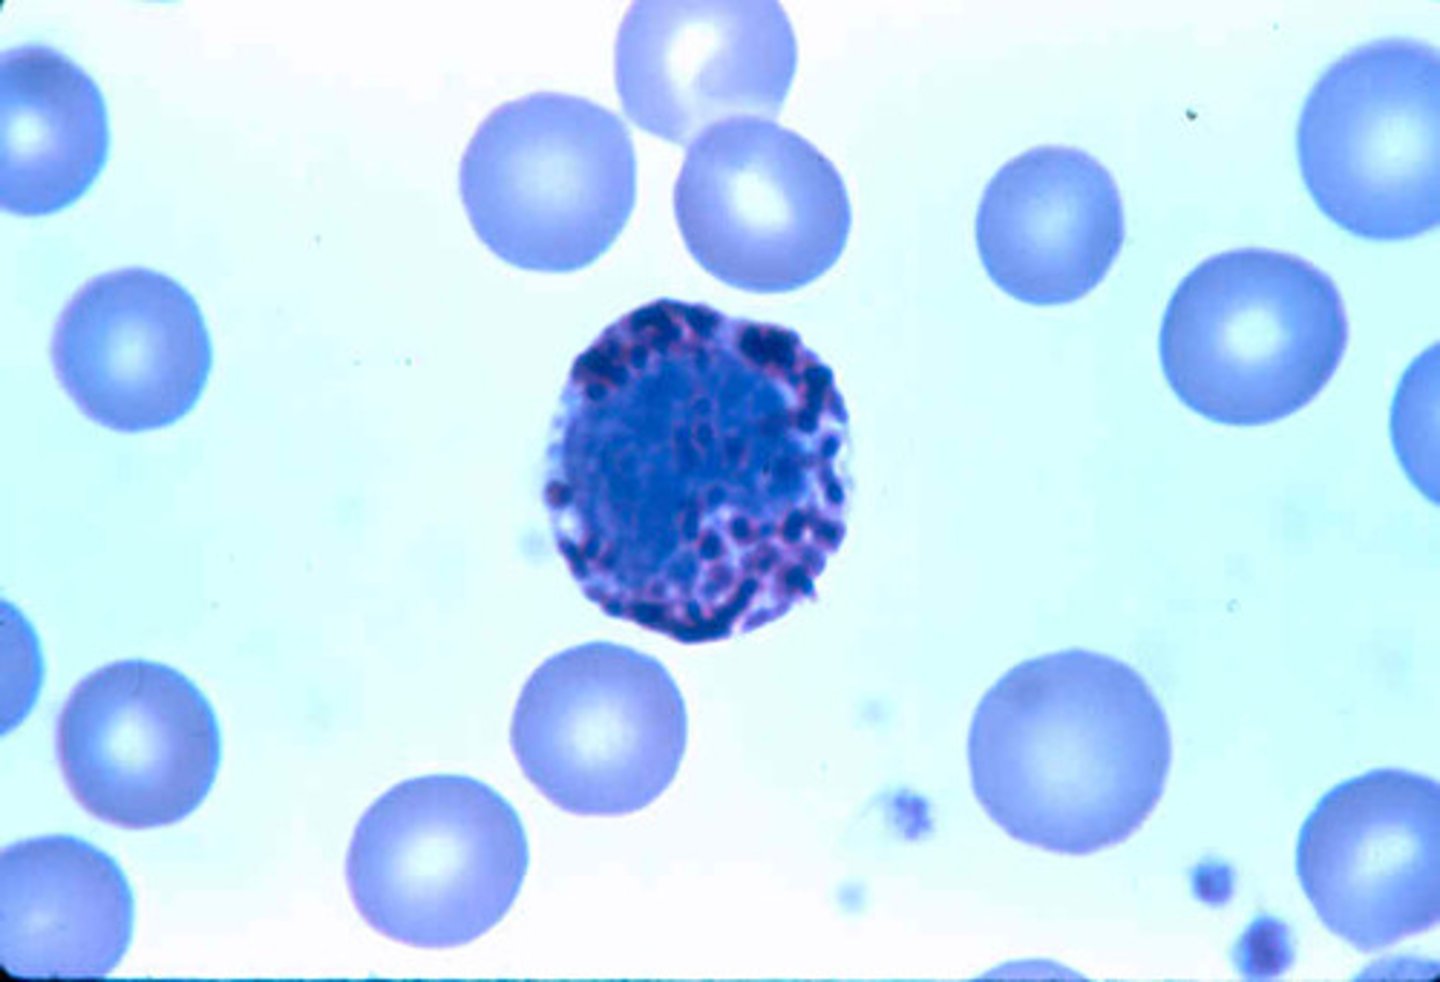
<p>define histology</p>
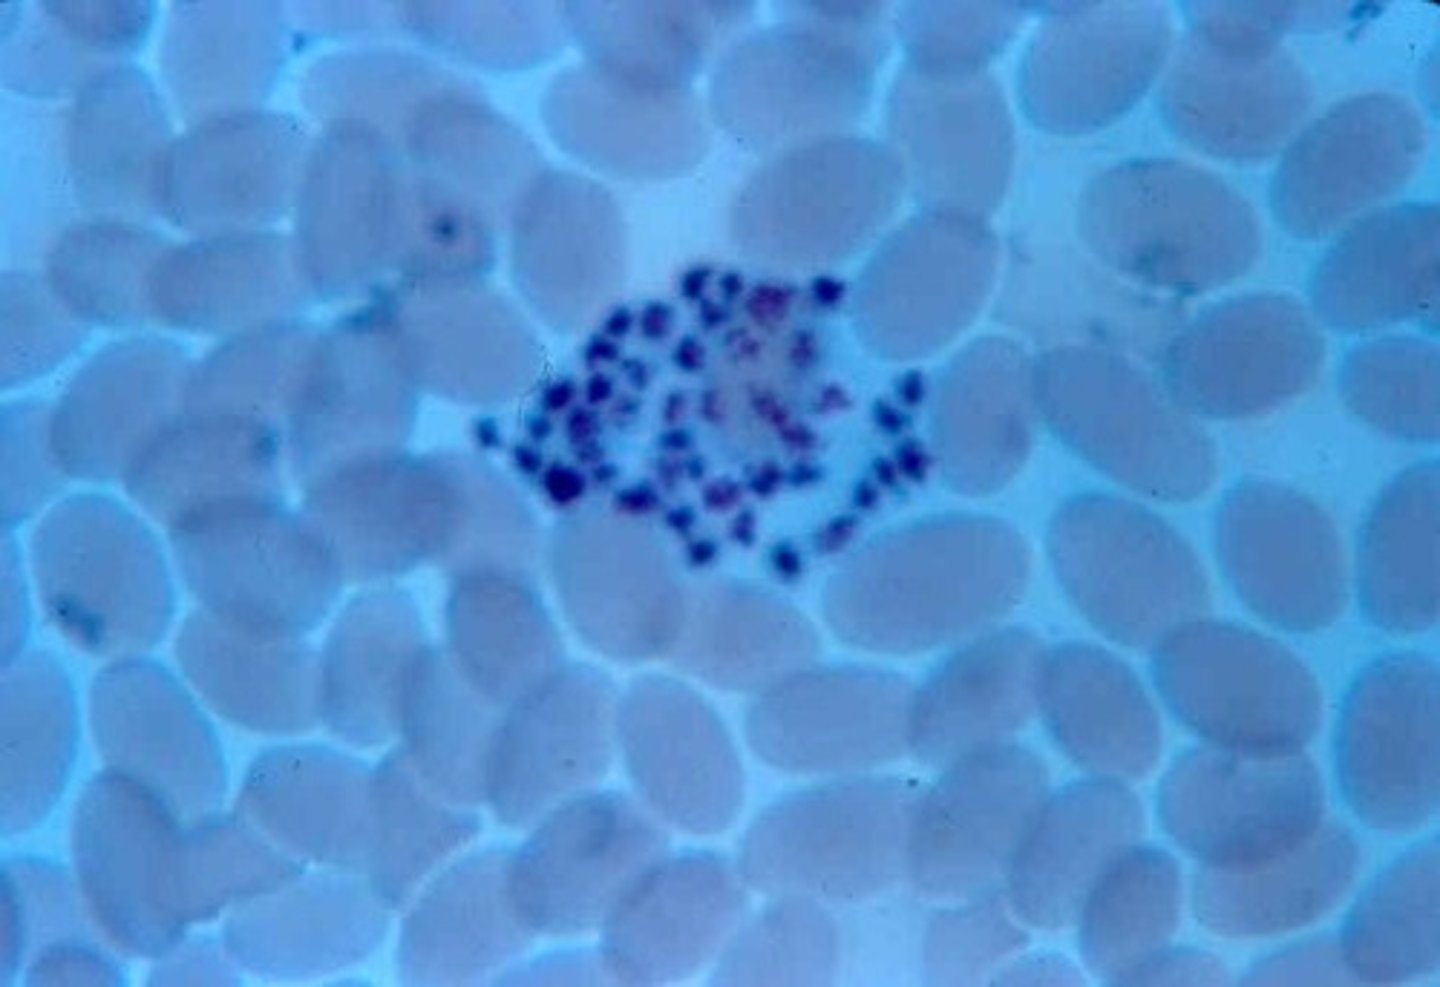
<p>define histology</p>

1/201
Looks like no tags are added yet.
Name | Mastery | Learn | Test | Matching | Spaced | Call with Kai |
|---|
No analytics yet
Send a link to your students to track their progress
blood human monocyte
define histology

blood human basophil
define histology
blood smear
define histology

blood with platelets
define histology
neutrophil
define histology

monocyte
define histology

eosinophil
define histology

lymphocyte
define histology

basophil
define histology

cardiac muscle with intercalated discs
define

superior vena cava
define 1

aortic valve
define 10

tricuspid valve
define 7

interventricular septum
define 2

left ventricle
define 4

right atrium
define 3

pulmonary valve
define 9

ascending aorta
define 5

left atrium
define 6

left subclavian artery
define 11

bicuspid valve
define 8

right ventricle
define 14

chordae tendineae
define 12

papillary muscle
define

right pulmonary arteries
define 13

apex
define 1A

left pulmonary artery
define 5A

pulmonary trunk
define 9A

right atrium
Define 3A

left ventricle
define 8A

aortic arch
define 2A

right ventricle
define 6A

left atrium
define 7A

aortic valve
define A

left ventricle
define D

chordae tendineae
define C

apex
define B

epicardium
define layer 2

endocardium
define layer 3

myocardium
define layer 1

artery
slide 1

vein
slide 2

artery
slide A

vein
slide B

lumen of artery
slide D

lumen of vein
slide C

aortic arch
define arrow

common carotid artery
define arrow

common iliac artery
define arrow

dorsal artery
define arrow

aorta
define arrow

subclavian artery
define arrow

brachiocephalic artery
define arrow

external jugular vein
define arrow

superior vena cava
define arrow

subclavian vein
define arrow

common iliac vein
define arrow

hard palate
define 4

trachea
define 1

tongue
define 3

soft palate
define 2

epiglottis
define 6

esophagus
define 5

larynx
define 7

diaphragm
2

left lung
3

trachea
1

right lung
4

larynx
C

secondary bronchi
G

trachea
A

thyroid cartilage
F

tracheal cartilage
D

cricoid cartilage
E

main bronchi
B

right middle lobe
3C

cardiac notch
6C

right inferior lobe
5C

left superior lobe
4C

left inferior lobe
2C

right superior lobe
1C

pseudostratified ciliated columnar epithelum
define histology

pseudostratified ciliated columnar epithelium
define slide

tracheal cartilage- hyaline cartilage
define histology

hyaline cartilage
B

pseudostratified ciliated columnar epithelum
A

trachea
define slide

tracheal hyaline cartilage
define slide

lung
define slide

alveoli duct
1D

single alveoli
3D

alveoli sacks
2D

hard palate
5Z

esophagus
1Z

epiglottis
3Z

tongue
2Z

pharynx
4Z

soft palate
6Z

liver
A

descending colon
E
